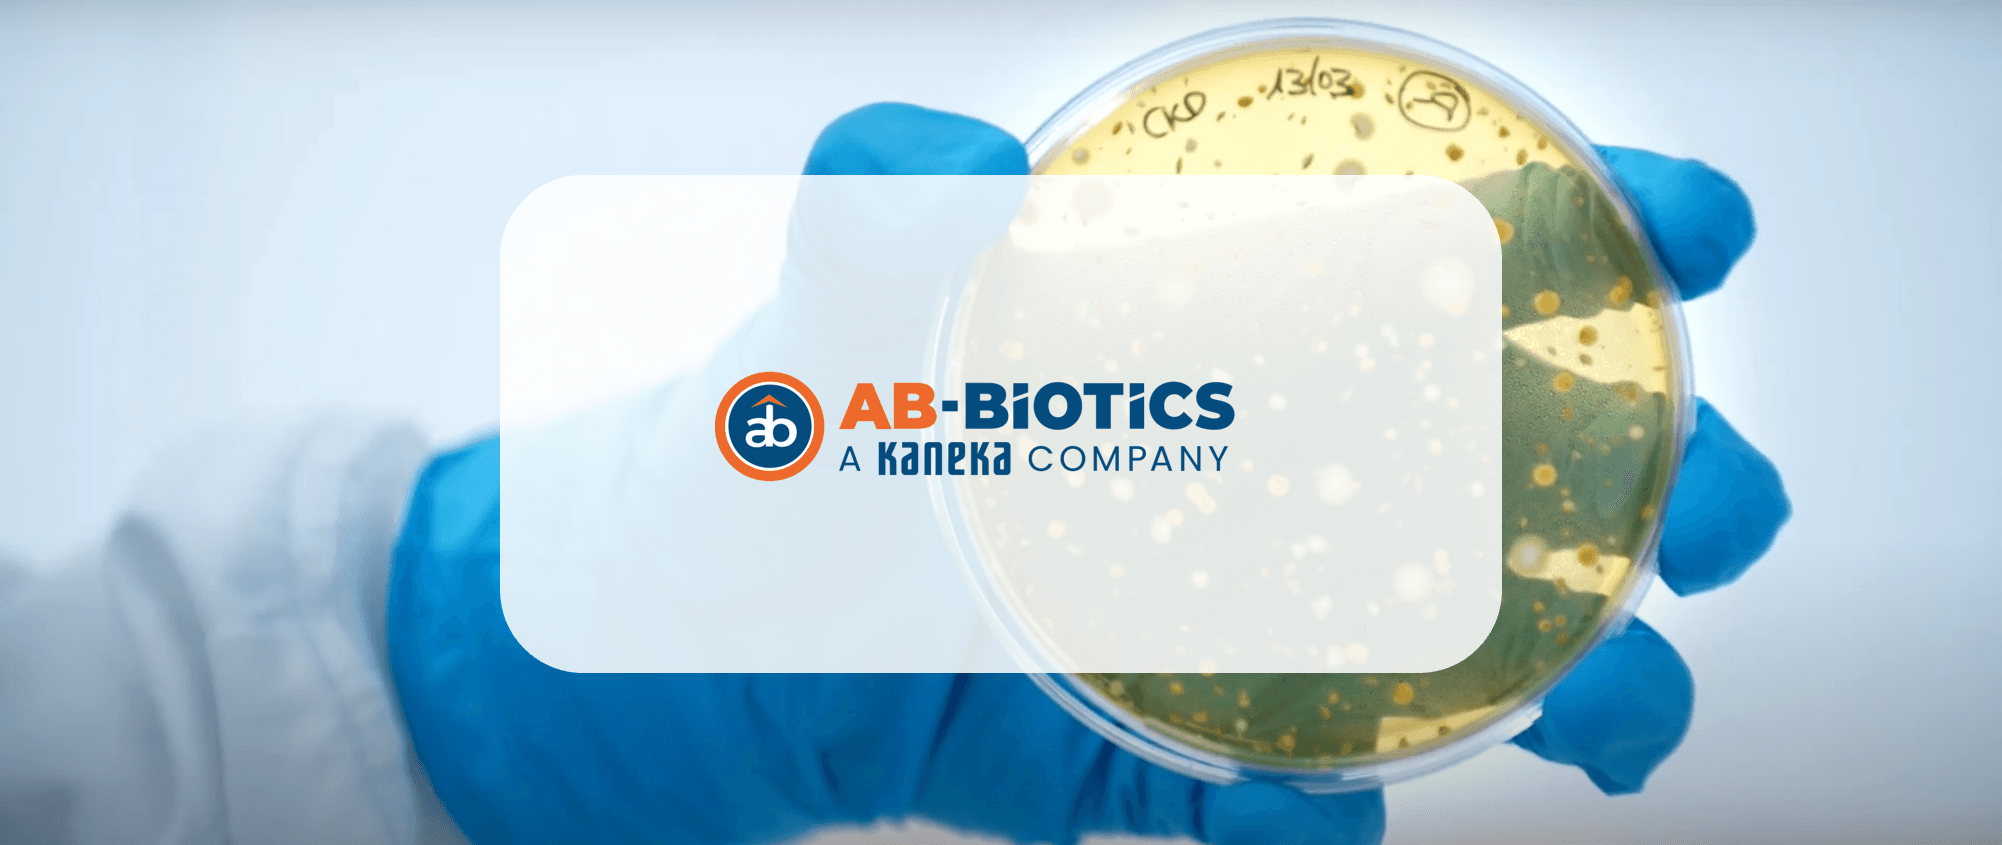

Ayudamos a las organizaciones en su transformación hacia la empresa inteligente, conectando procesos, departamentos y funciones a través de soluciones de gestión empresarial integral del negocio.
Gestionamos íntegramente el backoffice de la compañía, para tener visibilidad en tiempo real sobre el estado del negocio, siendo esto clave para la toma de decisiones y competir con éxito.
SICPA es el líder del mercado en tintas de seguridad y principal proveedor de soluciones de autenticación, identificación, trazabilidad y cadena de suministro.
El reto técnico de SEIDOR fue desarrollar un S/4HANA Brownfield con desarrollo de recetas, informes de grupo, SAC e implementación de Integration Suite. Desde enero de 2021 han estado involucradas 440 personas para llevar a cabo el proyecto en 21 países y 5 continentes.
Retos de negocio
Responder a las demandas y necesidades del mercado de forma ágil, eficaz y eficiente.
Competir utilizando el poder del dato, entendiendo mejor el negocio, y respondiendo en tiempo real.
Ejecutar de forma integrada los procesos de negocio, optimizando los recursos empresariales, ahorrando costes y ganando eficiencia.
Disponer de una visión analítica que permita analizar el negocio en tiempo real y optimizar la toma de decisiones.
Soluciones SAP Cloud ERP
¿Cuál es la diferencia entre SAP Cloud ERP y SAP Cloud ERP Private?
Actualmente, estas son dos de las soluciones tecnológicas de SAP que están ayudando a cada vez más empresas a iniciar o complementar su transformación digital. Con todo, hay quien se pregunta cuáles son las diferencias entre ellas y qué opción es más conveniente para su empresa.
Otras soluciones SAP ERP
La importancia de un ERP en la toma de decisiones
¿Sabes cuáles son los beneficios de un ERP en la toma de decisiones? ¡Te lo contamos todo aqui!
Nuestras soluciones
Quizá te puede interesar
S/4Hana Cloud: el ERP Inteligente en la nube de SAP
¿Qué es S/4Hana Cloud?
Es el ERP Inteligente en la nube de SAP. Actualmente estamos viendo indicadores claros de que el mercado está cambiando. De hecho, la mayoría de las firmas analistas predicen tasas de crecimiento de hasta el 20% en los próximos 24 meses para el mercado de Cloud ERP.